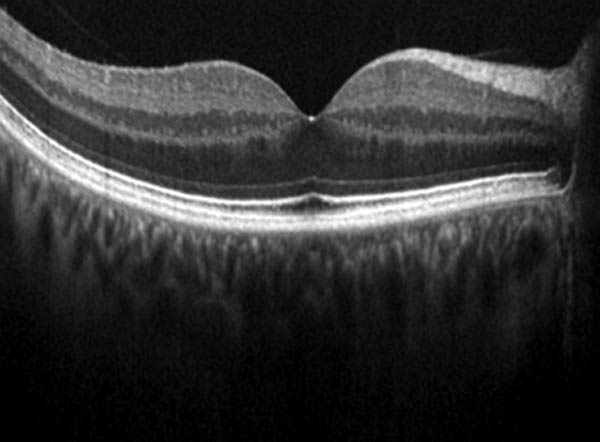

Minimize the challenges of comprehensive eye examinations with moving or nervous patients including infants and children with quick and sensitive real-time OCT imaging.
Capture the right data and acquire real-time, high-definition images the first time, every time. The Envisu C2300 OCT system provides both high-resolution and depth for examination of the detailed retina and cornea structures.

Get high-resolution and deep tissue imaging with a wide field of view using the Envisu C2300. Handheld, contact-free imaging offers you the full performance. The Envisu C2300 OCT system provides enhanced field of view, high quality optical imaging and allows you to see:

Each patient is unique and each eye is different. The Envisu C2300 OCT system is available with a wide range of lenses for all of your individual cases.
Choose from various lenses for posterior and anterior imaging. No matter the shape of the eye or the age of your patient, we can help you choose the right lens for your imaging.

Acquiring high-quality data and brilliant images is essential for providing an aid in diagnosis. This means you need to easily and reliably manage data with strict imaging protocols. Our InVivoVue 2.4OCT Management Software provides you with an outstanding user interface experience:
Hiện tại chưa có ý kiến đánh giá nào về sản phẩm. Hãy là người đầu tiên chia sẻ cảm nhận của bạn.